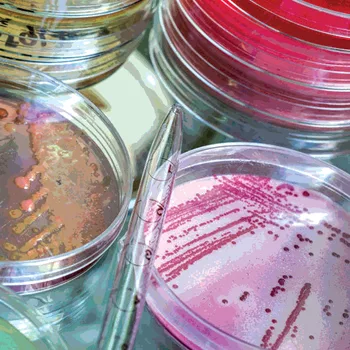

Getting Sanitation Out of the Reclean/Retest Rut
In recent years, food companies and regulators have become increasingly vigilant for environmental pathogens in manufacturing facilities, with problems triggering swab-a-thons and even recalls. This vigilance, coupled with advances in microbiological detection and updated epidemiological strategies, has discovered several direct links of these “plant bugs” to cases of foodborne outbreaks. Whole-genome sequencing has allowed regulators to verify these links and sharpen their focus on detecting and eliminating pathogenic contamination from the manufacturing environment. The two primary pathogens of concern are Listeria monocytogenes in wet processing environments and Salmonella in dry. Companies must utilize a combination of environmental monitoring program (EMP) testing and sanitation observation to understand the efficacy of their sanitation programs to deter pathogens from becoming resident in food plants.
Three main avenues exist for microorganisms to find their way into product during manufacturing: arriving via raw material ingredients, employees, or residential and transient microbes living inside the facility. The U.S. Food and Drug Administration's (FDA’s) Food Safety Modernization Act (FSMA) has made many food producers take a long look at their supply chain programs and employ comprehensive preventive measures to help prevent ingredient contamination. Improved training techniques and a focus on internal auditing have improved compliance with vital Good Manufacturing Practices that prevent employee contamination, especially better handwashing practices. Innovations with threshold sprayers depositing a nonslip sanitation foam in high-traffic areas prevent cross-contamination via footwear, forklifts, and rolling carts. Captive shoe programs (requiring that company-issued footwear is used and kept inside the plant) can also prevent contamination from walking through the door. Only this type of program can prevent the same shoes that fed the horses in the barn that morning from entering operations. The final frontier of contamination prevention is ensuring that transient microorganisms that somehow enter the plant do not establish permanent residency.
New Guidance from FDA
Environmental contamination garnered enough regulatory attention to warrant the creation of Draft Guidance for Industry: Control of Listeria monocytogenes in Ready-To-Eat Foods (RTE), which was released in January 2017. In this document, FDA urges RTE plants to identify and eradicate L. monocytogenes “whenever an RTE food is exposed to the environment prior to packaging and the packaged food does not receive a treatment or otherwise include a control measure (such as a formulation lethal to L. monocytogenes) that would significantly minimize L. monocytogenes.”1 The guidance charged manufacturers to create an action plan when positives were found, to go above and beyond the old “reclean and retest” mantra that has been the staple of EMPs for years.
This guidance document also prompted manufacturers to take another look at their EMPs and offered several solid strategies to seek and eradicate sources of contamination. Finding the source of the contamination was a factor often missing in many EMPs. Plants will see sporadic Listeria positives arising in multiple locations in the same room, only to disappear and reappear somewhere else. Identifying and destroying the source is the key to eliminating these sporadic positives and ensuring that the problem has been sufficiently solved. Vector swabbing, or placing surrounding areas on a grid and systemically testing them, is one of the best tools for true source identification. A positive found underneath an equipment frame could have originated in a drain, which could be spread to another room by a roller cart. It is important to look at surrounding areas and transient surfaces (like a forklift, pallet jack, or employee footwear) that often pass through an area. Fans, entry curtains, and high-pressure hoses can also spread contamination great distances in plants. Once the source of the positive is identified, the next step is to destroy it and ensure that preventive measures are sustained. This will often take special cleaning and might require outside resources, such as fogging, or renting special equipment to ensure that the problem is eradicated.
Strategizing Your EMP for Efficacy
A huge inhibitor to a robust EMP is the potential liability to finding a positive pathogen test result, especially on a food contact surface or in product. Government agencies such as FDA and the U.S. Department of Agriculture have tried to write regulations and guidances to allow plants the opportunity to “seek and destroy” contamination. However, EMP-based recalls, the high cost of testing, and the general litigious nature of our country have discouraged all but a few brave companies from employing a truly robust EMP. The old adages, “you can’t un-ring a bell” and “you can’t un-learn what you learn” are often quoted when discussing extended testing sites to encompass vulnerability points. The problem with this mentality is that it is not sustainable, and unless the sanitation program is bulletproof, avoiding an EMP altogether could be disastrous for a company. Ironically, the companies with the most robust EMP and sanitation problem-solving programs are often those that have gone through a catastrophic contamination event. They offer a cautionary tale of how the strategy of avoidance can ultimately prove to be disastrous.
It is not necessary to wait for a positive pathogen test result to indicate that a problem exists within a sanitation program. The most robust swabbing program can fail if the proper sites are not swabbed, if data are not properly analyzed, and if conclusions are not communicated to the correct departments. Microbiological data and observations should be trended over time to identify negative tendencies and tackle potential issues before they escalate into true problems. Testing for indicator organisms, such as coliforms and Enterobacteriaceae, and graphing these micro-results can offer a window into the microbial health of equipment and wider plant areas. Another great approach is trending preoperational observations. Simply list all the sites and calculate how many unsatisfactory results occur each month. This will not only provide an indication on the equipment that is harder to clean, but can also trigger red-flag alerts to sanitation employees who might be struggling with their areas. Routinely going through these results with both the operational and sanitation staff can give new insight into root causes and generate ideas for solutions.
The best strategy when selecting environmental swabbing sites is to think like the pathogen being targeted. Just think: “WWSD?” or "What Would Salmonella Do?" This triggers the question, “Where would Listeria and Salmonella really thrive inside the plant?” The problem with most microbial swabbing programs is that they are not designed to actually find these tricky organisms. Companies often go through the motions of an EMP to comply with a regulation, audit, or customer requirement. They are swabbing to satisfy, not swabbing to identify. Site swabbing lists are often easy-to-reach, flat surfaces, for which swabbing is repeated month after month. Is the stainless steel tabletop that is easy to reach and clean a good swabbing site, or should the cleaning crew be challenged by selecting hard-to-reach and hard-to-clean locations?
Challenges to Developing a Robust EMP
Often, contamination from environmental pathogens is the result of failure to properly address issues with facility cleaning practices. Thorough sanitation is among the most important means of preventing this type of contamination, but it is often not robust enough to properly identify and solve these problems. Plants often do not have adequate preventive actions, just an immediate corrective action "bandage" to make the positive test results go away for the next retest. A multitude of root causes exist for improper sanitation. It could be a problem with the staff, an incorrect procedure, or an improper frequency; or maybe the equipment was not built with sanitary design in mind, an incorrect chemical is being utilized, or a chemical is being used in an incorrect manner. Getting to the real root of the problem is the best way to truly prevent contamination from taking root inside a facility.
Good sanitation is the cornerstone of a solid, preventive food safety program, but it is agonizing how often “retrain sanitation staff” is listed as the preventive measure for a sanitation issue. While training is always a good idea, simply going through the cleaning procedures for that piece of equipment might not really address the issue. Is that sanitation individual the right person for that piece of equipment or area of the room? Do they truly understand the hard-to-reach areas for their location? Is anyone observing them to ensure that they know the cleaning procedures and are executing them properly on an ongoing basis? Maybe they have a day job and are just too tired to really be effective? Maybe it is not their fault at all; maybe the problem is something else. The most commonly used sanitation corrective actions—reclean, retrain, and reswab—rarely fix the problem because they never actually identify the root cause of the issue. Unfortunately, those three words appear on so much sanitation paperwork that they have become routine in far too many plants.
Management
One of the most frequent failures of a good sanitation program has little to do with the sanitors, procedures, or chemicals: it is a general lack of management observation and attention. The biggest vulnerability of these programs is that they are often overlooked—the "neglected stepchildren" of a food safety plan. Pure inconvenience is the primary reason that these vital activities do not garner more focus. While many plants schedule sanitation activities around the clock, most dedicate this vital task to third-shift employees, reserving as many precious daylight hours to operations as possible. The sad fact is that management rarely venture past their normal hours of operation to experience the challenges that their sanitation crews face on a daily (or nightly) basis. While FSMA has tried to bring it into the light by naming it a common preventive control, it is still a secondary concern to most food safety and operations managers. Management is not the only party to blame. How often is third-shift sanitation on the docket for internal, corporate, second-party, or third-party audits? An auditor might venture out early enough to observe a preoperational inspection, but will rarely spend the night in the plant to understand one of the programs most vital to food safety.
The underlying fact is that both quality/food safety and operational management should be observing the performance of cleaning on a regular basis to offer encouragement, coaching, and support to their sanitation crews. To make the most of this time, an expert can be brought in to observe sanitation activities, such as a chemical company representative or a sanitation consultant. Properly observing sanitation activities is a skill that needs to be taught and practiced, just like anything else. The eye must be trained to spot inconsistencies and potential problems that could escalate to become major issues. A sanitation monitoring program that solely relies on environmental (or ATP) testing is insufficient. It must also include plenty of opportunities for observation, during both a routine, preoperational inspection and actual time directly observing the cleaning procedures. Most food operations include complex equipment, and if preoperational inspections are not finding unacceptable observations on a regular basis, then questions should be asked about whether they are adequately verifying the correct sites or if negative observations are not making their way into the paperwork. Preoperational worksheets should be extensive and never include an entire piece of machinery in one entry.
Training
If additional training is required, Richard Buchman, an expert consultant and sanitor who has nearly 30 years of experience in the sanitation field, offers some advice. He suggests keeping it simple and focusing on the most important items: temperature of rinse water, action (hand scrubbing or clean-in-place velocity), contact time/coverage of the chemicals, and proper chemical concentration, or titration. The acronym, TACT, is an easy way for employees to remember these vital cornerstones of proper sanitation. Buchman is also a strong advocate for management observation and suggests asking the sanitation leader what percent of surfaces are being sanitized and verifying that answer with direct observation. Every cleaning crew should adopt the slogan “100 percent of surfaces cleaned and sanitized, every day.” Is cleaning/sanitizing 85 percent of surfaces adequate? When it comes to sanitation, companies often have the misguided mentality of “everything is good ... until it isn’t.” It is much more efficient to conduct firsthand observations and identify warning signs before a crisis arises. Increases in unacceptable microbial testing results and preoperational observations are easy warning signs, but there are others to look for. An increase in cleaning crew turnover and a decrease in chemicals usage could also be red flags that problems are brewing.
Equipment Design
Occasionally, the preventive measure is not an easy one, and an issue arises with the equipment’s basic design that makes it uncleanable. Maybe it cannot be properly dismantled, is composed of materials that are impossible to clean, or is hard to reach for the sanitation crew. One of the most dreaded phrases in all of operations is, “this problem is going to take a capital expenditure to fix.” This emphasizes the importance of engineers, quality, and/or operations carefully reviewing the blueprints and specifications for new equipment to ensure that it meets proper sanitary design. Can this new piece of equipment be easily and effectively cleaned, and more importantly, can it be cleaned on a frequent and ongoing basis? Before existing equipment is totally redesigned, an alternative form of cleaning should be tried, such as fogging. Unfortunately, sometimes the only answer is to redesign or replace the equipment altogether.
Lack of Expertise
Sometimes a problem cannot be fixed in-house, and outside resources must be located to help. Many of these resources are readily available and are not being properly utilized. When an issue arises that cannot be easily solved, it is always a good idea to find an expert. A wonderful resource that is already associated with most medium and large plants is the local chemical company representative. These hardworking folks have years of knowledge on cleaning all types of equipment and plants. Often, the problem is not the cleaning technique or the frequency, but simply that the wrong type of chemical is being used, at the incorrect concentration, or in the incorrect manner.
Takeaways
The biggest problem with sanitation problem-solving is the general lack of vigilance and effective solutions. Most plants are so happy in their routine of “reclean, retrain, and reswab” that they rarely identify the actual root cause, and in the instances where the true source is identified, sustainable preventive measures are not enacted. An “out of sight, out of mind” approach to cleaning has often been a deadly mistake and has led to pathogen positives, contamination events, recalls, and even foodborne illness outbreaks. Good companies have lost everything due to a lack of concern and oversight for this vital piece of the food safety program.
Wendy White, M.Sc., is the Food and Beverage Industry Manager for the Georgia Manufacturing Extension Partnership (GaMEP) at Georgia Tech. She holds a B.S. degree in Biology and an M.Sc. degree in Food Microbiology from the University of Georgia and is an FSPCA PCQI Human Foods Lead Instructor, an International HACCP Alliance Lead Instructor, and an ASQ Certified Quality Auditor. She is also a member of the Editorial Advisory Board of Food Safety Magazine.
Reference
1. U.S. Food and Drug Administration. Draft Guidance for Industry: Control of Listeria monocytogenes in Ready-to-Eat Foods. January 2017. www.fda.gov/regulatory-information/search-fda-guidance-documents/draft-guidance-industry-control-listeria-monocytogenes-ready-eat-foods.
Looking for quick answers on food safety topics?
Try Ask FSM, our new smart AI search tool.
Ask FSM →






